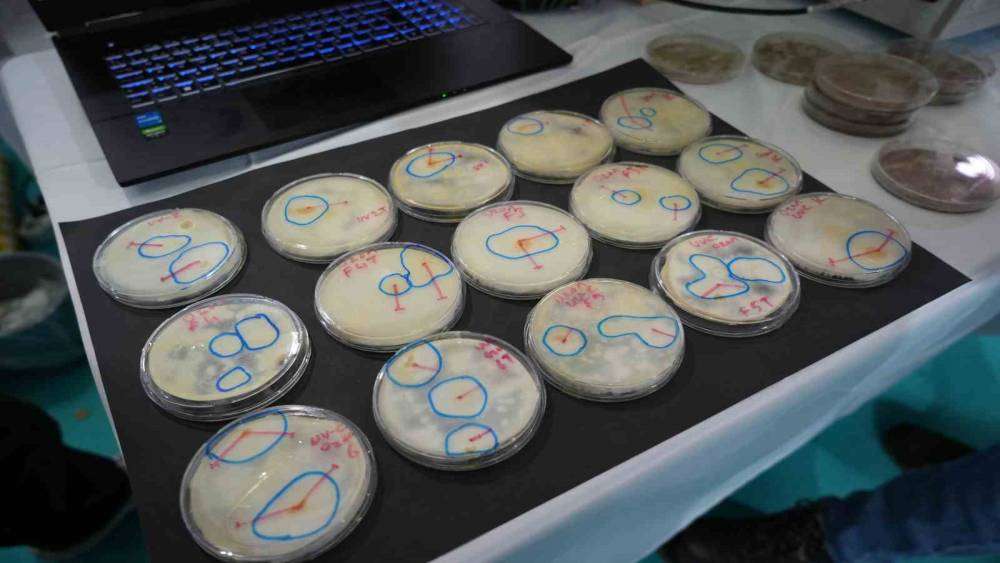

Lise öğrencileri kapalı ortamları sterilize edecek cihaz ve odun külünden sirke üretti
Lise öğrencileri kapalı ortamları sterilize edecek cihaz ve odun külünden sirke üretti
Samsun’da düzenlenen yarışmada lise öğrencileri yaptıkları projeleri sergiliyor.
Samsun’da faaliyet gösteren bir okul, kapalı ortamları sterilize edecek cihaz yaptı. Ordu’da bir özel okul öğrencileri de odun külünden sirke üreterek kedi kumunu daha steril hale getirmeyi amaçladı.
Ondokuz Mayıs Üniversitesi (OMÜ) ev sahipliğinde düzenlen "Lise Öğrencileri Araştırma Projeleri Bölge Yarışması" devam ediyor. Samsun Atakum Bilim Sanat Merkezi öğrencilerinden Yaşar Yiğit Toraman, Kerem Bekdemir, Nevin Emek Avcı, ’Otonom Ortam Sterilizasyon Sistemi’ adını verdikleri bir proje yaptı. Proje çerçevesinde öğrenciler, UVC radyasyonu ve ozon gazını kullanan bir cihaz geliştirdi. Proje hakkında bilgi veren Yaşar Yiğit Toraman, "Projemiz amacı kapalı ortamları temassız bir şekilde UVV radyasyonu ve ozon gazının kanıtlanmış antimikrobiyal yeteneklerini kullanarak sterilize etmektedir. UVC radyasyonu ve ozon gazını tercih etme sebeplerimiz ikisinin de doğal, kalıntı bırakmayan dezenfektanlar olmasıdır. Sistemimiz bu dezenfeksiyon sisteminin yanında insan algılama sistemi barındırmaktadır. Bu insan algılama sisteminin olayı da ozon gazı ve UVC radyasyonunun zararlı etkilerinden insanları sakınmaktır. Bu sistem çalışırken odaya herhangi bir insan girdiğinde insan algılama sistemimiz insanı anında algılamakta, sistemi direk durdurmaktadır. Bu sistemi deneyler ile kanıtlamış bulunmaktayız. Hastane ortamları, hastane odaları, poliklinikler, MR odaları, ameliyathane odaları bir sürü yerde kullanılabilecek bir sistemdir. Normalde baktığımızda sadece ozon gazının maliyeti 18-20 bin TL iken, bizim cihazımız bir UVC sistemi, ozon sistemi, insan algılama sistemini toplamda 25 bin TL’lik bir maliyet getiriyor. Zamandan tasarruf sağlıyor. 10 dakika boyunca UVC yapması, 25 dakika ozon jeneratörünün çalışması gerekiyor. Bu şekilde 40 dakika içinde bir ortamı sterilize edebiliyor" dedi.
Odun külünden sirke
Ordu bulunan bir özel lise öğrencileri Bilgenur Altun ve Dilay Ceren Çekver, odun külünü sirke yaparak, kedi kumunu daha steril hale getirmeyi amaçladı. Proje hakkında bilgi veren Dilay Ceren Çekver, "Odun külünün kedi kumundaki potansiyelini araştırıyoruz. Odun külümüzü değirmenlerde çektirerek, ardından meşe odunumuzu sıcak bir şekilde elma suyuna ilave ederek üstüne kaya tuzumuzu ve balımızı ilave ederek 6 ay beklettik. Sirke elde ettik. Bu odun külü sirkemizi alternatif tıp yanında hayvan dostlarımıza yardım amaçlı kullandık. Hayvan dostlarımıza hem daha iyi bir hijyenik ortam sağlayabilmek hem de onları için ekosisteme faydalı bir ortam oluşturmak istedik" diye konuştu.
"Alternatif tıpta kullanılabilir"
Bilgenur Altun ise "Odun külü sirkemizi spreyleme yöntemi ile kedi kumuna aktardık. Aktarma işlemi sonucunda kedi kumunda anti bakteriyel özelliğinin çok fazla olduğunu görmüş olduk. Bu projemizde odun külü sirkemizi ön plana çıkarmayı amaçladık. Odun külü sirkesini çevremizde aldığımız duyumlar üzerine alternatif tıpta çok önemli bir özelliğini görmüş olduk. Odun külü sirkesinin göbek bölgesi çevresindeki yağları erittiği, grip gibi salgın hastalıklara iyi geldiği, damar tıkanıklığı ve benzeri rahatsızlıklara alternatif tıp için bir çözüm olduğu duyumunu aldık. Bunun araştırılması gerekiyor" diye konuştu.
Yorumunuz başarıyla alındı, inceleme ardından en kısa sürede yayına alınacaktır.